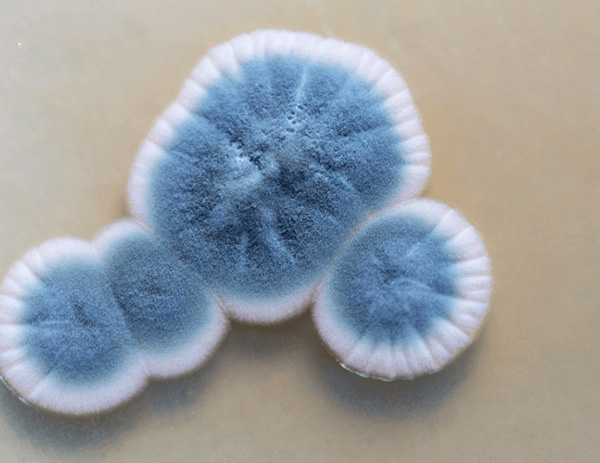
Hình thái nấm mốc hiển thị hệ sợi nấm

Nấm men và nấm mốc là hai nhóm sinh vật nhân thực phổ biến, đóng vai trò kép: vừa là nhân tố tạo nên những sản phẩm lên men thơm ngon, vừa là tác nhân gây hư hỏng và ngộ độc thực phẩm. Bài viết này, MT sẽ tìm hiểu về nấm men và nấm mốc từ đặc điểm sinh học, sự khác biệt giữa chúng trong thực phẩm, đến các ứng dụng thực tiễn trong sản xuất và chế biến.

Tổng quan nấm men
Nấm men (Yeasts) là các vi sinh vật đơn bào thuộc lớp Ascomycetes.
- Hình thái: Thường có hình cầu, hình bầu dục hoặc hình trứng.
- Kích thước: Rất nhỏ, dao động từ 3-10µm, chỉ quan sát được dưới kính hiển vi.
- Sinh sản: Chủ yếu bằng hình thức nảy chồi (budding) hoặc phân đôi.
- Môi trường: Ưa thích môi trường lỏng hoặc ẩm ướt có chứa đường và tính axit nhẹ.

Tổng quan nấm mốc
Nấm mốc (Molds) là tên gọi chung của các loại nấm dạng sợi (filamentous fungi).
- Hình thái: Là vi sinh vật đa bào, cấu tạo từ các sợi nấm (hyphae) tạo thành hệ sợi nấm (mycelium). Chúng ta có thể quan sát nấm mốc bằng mắt thường dưới dạng các mảng lông tơ hoặc bột.
- Sinh sản: Phát triển và lan truyền chủ yếu bằng bào tử (spores). Các bào tử này rất nhẹ, dễ dàng bay trong không khí.
- Môi trường: Phát triển mạnh ở nơi có độ ẩm cao, nhiệt độ ấm áp và trên bề mặt thực phẩm hữu cơ.
Đọc thêm các bài viết liên quan:
Sự khác biệt giữa nấm men và nấm mốc trong thực phẩm
Dưới đây là bảng so sánh hình thái, đặc tính sinh lý nấm men và nấm mốc như:
| Tiêu chí so sánh | Nấm men (Yeasts) | Nấm mốc (Molds) |
| Cấu tạo tế bào | Đơn bào (Unicellular). | Đa bào (Multicellular), dạng sợi. |
| Hình thái quan sát | Dạng kem, nhớt, bọt khí, màng trắng trên bề mặt lỏng. | Dạng bông, sợi, lông tơ, có nhiều màu sắc (xanh, đen, cam…). |
| Phương thức sinh sản | Nảy chồi hoặc phân cắt tế bào. | Sinh sản vô tính hoặc hữu tính bằng bào tử. |
| Màu sắc khuẩn lạc | Thường là màu trắng đục, vàng kem. | Đa dạng: Xanh lục, đen, trắng, cam, đỏ… |
| Điều kiện pH tối ưu | pH 4.0 – 4.5 (ưa axit). | pH 3.5 – 5.0 (dải pH rộng hơn). |
| Nhu cầu oxy | Kỵ khí tùy tiện (có thể sống khi thiếu oxy). | Hiếu khí bắt buộc (cần oxy để phát triển). |
| Dấu hiệu nhận biết trên thực phẩm | Sủi bọt khí, xuất hiện lớp váng nhớt hoặc màng màu trắng đục trên bề mặt chất lỏng. | Xuất hiện các đốm lông tơ, dạng bông xốp với nhiều màu sắc (xanh, đen, xám, trắng…). |
| Mùi đặc trưng | Mùi rượu (do lên men tạo cồn) hoặc mùi chua nồng. | Mùi ẩm mốc, hôi thối đặc trưng. |
| Môi trường thực phẩm thường gặp | Thường gặp trong thực phẩm lỏng hoặc có hàm lượng đường cao: Nước trái cây, mật ong, dưa muối. | Thường gặp trên bề mặt thực phẩm rắn và mềm: Bánh mì, phô mai, trái cây, các loại hạt. |
| Cơ chế gây hại chính | Gây nhiễm trùng trực tiếp (ví dụ: Candida albicans) gây viêm, tưa lưỡi, tiêu chảy. | Sản sinh độc tố Mycotoxins (Aflatoxin, Ochratoxin…) gây ngộ độc và ung thư. |
| Đặc tính độc tố | Ít đề cập đến độc tố bền nhiệt, chủ yếu gây bệnh do sự xâm nhập của tế bào nấm. | Độc tố bền với nhiệt độ, không bị phân hủy khi nấu chín thông thường (kể cả 100°C). |
| Tác hại sức khỏe | Đau bụng, tiêu chảy, nấm miệng. Nguy hiểm gây nhiễm trùng huyết ở người suy giảm miễn dịch. | Buồn nôn, suy gan, suy thận, ung thư gan (do Aflatoxin), dị ứng hô hấp. |
| Ứng dụng có lợi | Sản xuất bia, rượu vang (chuyển hóa đường thành cồn), làm bánh mì nở xốp (tạo CO2). | Sản xuất phô mai (Blue cheese, Camembert), enzyme, axit hữu cơ và thuốc kháng sinh (Penicillin). |
| Cách xử lý khi nhiễm | Thường vứt bỏ do thực phẩm lỏng đã bị biến đổi chất lượng toàn bộ. | Thực phẩm mềm/xốp cần vứt bỏ ngay. Thực phẩm cứng có thể cắt bỏ phần mốc (rộng ra 2.5cm) và tiếp tục sử dụng. |
Ứng dụng của nấm men và nấm mốc trong thực phẩm
Nấm men và nấm mốc được ứng dụng rộng rãi trong công nghiệp thực phẩm, đặc biệt trong các quá trình lên men nhằm tạo hương vị, kết cấu và giá trị dinh dưỡng cho sản phẩm. Cụ thể:
Ứng dụng của nấm men
Nấm men được dùng chủ yếu trong:
- Làm bánh: Nấm men tạo khí CO₂ trong quá trình lên men đường, giúp bột nở và mang lại kết cấu xốp, hương thơm đặc trưng cho bánh mì và bánh ngọt.
- Sản xuất đồ uống có cồn: Chuyển hóa đường thành ethanol trong quá trình sản xuất bia, rượu vang và các loại rượu mạnh.
- Sản phẩm lên men: Được sử dụng trong sản xuất các thực phẩm lên men như sữa chua, tương và nước tương, góp phần tạo hương vị đặc trưng.
- Thực phẩm bổ sung: Nấm men chiết xuất giàu protein, vitamin nhóm B và khoáng chất, đồng thời tạo vị umami tự nhiên cho nước dùng và súp.
- Cải thiện giá trị dinh dưỡng: Hỗ trợ phân hủy axit phytic, qua đó nâng cao khả năng hấp thu khoáng chất trong thực phẩm.
Ứng dụng của nấm mốc
Nấm mốc có nhiều ứng dụng quan trọng trong việc:
Tạo hương vị và kết cấu đặc trưng:
- Phô mai xanh, Camembert, Brie: Nấm mốc tham gia phân giải protein và chất béo, giúp hình thành kết cấu mềm mịn cùng hương vị đặc trưng.
- Nước tương, rượu sake: Một số loài nấm mốc (như Monascus) góp phần tạo màu sắc tự nhiên và hương vị phức hợp cho sản phẩm.
- Xúc xích truyền thống: Nấm mốc bề mặt (ví dụ Penicillium nalgiovense) tạo lớp màng bảo vệ, hỗ trợ bảo quản và phát triển hương vị.
Sản xuất enzyme: Nấm mốc là nguồn cung enzyme quan trọng phục vụ nhiều công đoạn trong công nghiệp thực phẩm.
Sản xuất kháng sinh: Một số loài nấm mốc được sử dụng để sản xuất penicillin, loại kháng sinh có giá trị y học cao.

Nhìn chung, việc ứng dụng nấm men và nấm mốc mang lại giá trị lớn cho ngành thực phẩm, song cần được kiểm soát chặt chẽ nhằm đảm bảo chất lượng sản phẩm và an toàn cho người tiêu dùng.
Địa chỉ cung cấp giải pháp lên men đạt chuẩn
Giữ sự khắt khe về tiêu chuẩn chất lượng của ngành công nghiệp thực phẩm và dược phẩm ngày nay, việc sở hữu dây chuyền sản xuất hiện đại và quy trình kiểm soát vi sinh chặt chẽ luôn được ưu tiên hàng đầu. Đặc biệt với các doanh nghiệp ứng dụng công nghệ vi sinh như sản xuất bia, vaccine, chế phẩm sinh học.
Giữa hàng trăm đơn vị cung cấp giải pháp lên men trên thị trường, MT tự hào là đơn vị chuyên cung cấp các giải pháp toàn diện cho ngành công nghệ sinh học và thực phẩm uy tín hàng đầu tại Việt Nam.
Tại sao nên lựa chọn giải pháp từ MT?
- Công nghệ tiên tiến: MT cung cấp các hệ thống bồn lên men (Fermenter/Bioreactor) đạt chuẩn quốc tế, phù hợp cho cả nuôi cấy nấm men và các chủng vi sinh khác, đảm bảo kiểm soát chính xác các thông số nhiệt độ, pH, DO (oxy hòa tan).
- Thiết bị xử lý và kiểm soát: Cung cấp các thiết bị lọc, ly tâm và xử lý hậu lên men, giúp thu hồi sản phẩm tinh khiết và loại bỏ các tạp chất hoặc vi sinh vật không mong muốn (như nấm mốc tạp nhiễm).
- Tư vấn chuyên sâu: Đội ngũ kỹ thuật viên giàu kinh nghiệm sẵn sàng hỗ trợ doanh nghiệp thiết lập quy trình sản xuất tối ưu, từ quy mô phòng thí nghiệm đến sản xuất công nghiệp.
Để tìm hiểu thêm về các thiết bị và giải pháp kỹ thuật giúp nâng cao hiệu suất lên men và đảm bảo an toàn thực phẩm, bạn có thể tham khảo chi tiết tại website https://mtenequip.com/vi/home/ chính thức của chúng tôi.

Nấm men và nấm mốc là một phần không thể tách rời của hệ sinh thái thực phẩm. Việc phân biệt rõ đặc điểm của từng nhóm, nhận thức đầy đủ về nguy cơ từ độc tố nấm mốc trong thực phẩm, đồng thời bảo vệ sức khỏe cộng đồng và gìn giữ uy tín thương hiệu. Dù ở vai trò người tiêu dùng hay nhà sản xuất, việc trang bị kiến thức về các vi sinh vật này luôn là nền tảng cần thiết và lâu dài. Mọi thắc mắc về thiết bị lên men đạt chuẩn GMP, vui lòng liên hệ đến hotline: 0767.067.567 để được MT giải đáp!
